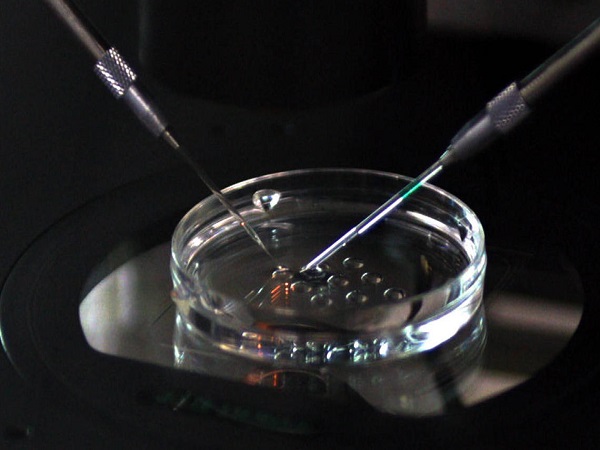

攻略贴:试管婴儿融合胚胎什么意思?一分钟带你轻松读懂
- 试管婴儿经验
- 2023-03-22 13:41
我们都知道,在试管婴儿取卵配成胚胎之后,实验室操作人员就会根据胚胎的质量、细胞数量等进行等级划分,一般分为一级、二级、三级和四级。还有一种名为融合胚胎的,融合胚胎其实就是胚胎在8细胞期过渡到16细胞时发生了致密性,这个时候胚胎的内部细胞和外部细胞都有了很大的变化,逐渐发育成了囊胚的内外两组细胞成分。
胚胎分为一级、二级、三级和四级
先怀孕,后付款-出生才是硬道理47岁1个卵泡一次成功经验分享不出国做三代-疫情下的试管新对策57岁供卵试管婴儿成功经验分享
助孕交流群
方法/步骤
众所周知,试管婴儿的成功率和胚胎的质量其实还是有一定关系的,胚胎的等级越高,质量越好,移植的成功率也就越高,反之如果胚胎的等级和质量比较差的话,那么就会对试管移植的成功率造成较大的影响,降低试管的成功率。
一般来说一级和二级胚胎是比较优质的,是非常适合进行试管移植的,移植的成功率也是比较高的。三级胚胎的质量相对来说比较一般,但是也是可以进行移植的,妊娠率也并不会太差,四级胚胎的质量非常差,是不可移植的胚胎。
胚胎等级越高移植的成功率越高
由此可见,试管婴儿移植的成功率和胚胎的质量是挂钩的,建议大家积极的调理自己的身体,只有精子和轮子的质量达标之后,胚胎的质量才能更好,移植的成功率也才能有所提升。
试管婴儿融合胚胎什么意思
融合胚胎在试管婴儿中其实是比较常见的,是胚胎在8细胞向16细胞过渡的时候发生了一定的变化。胚胎中无法看到单个圆形的卵裂球,卵裂球之间有细胞黏附分子连接在了一起,这个时候胚胎中的内部细胞和外部细胞也发生了改变,逐渐发育成为了囊胚的内外细胞成分。
也就是说,融合胚胎其实是囊胚前期,一般来说胚胎要想发育成为囊胚就都是需要经过融合这一步的,融合是胚胎发育的必经之路,同时也是胚胎发育比较良好的表现,因此融合胚胎的质量其实是比较好的,具有较高的发育潜能。
融合胚胎就是8细胞向16细胞过渡时发生了变化
换句话说,其实融合胚胎的质量还是比较好的,但是需要知道的是融合胚胎和囊胚还是有区别的,是完全不同的胚胎,发育的时间段也存在不同,融合胚胎还没有达到囊胚的阶段。
Tips:
随着时间的推移,有的融合胚胎可能会慢慢的达到囊胚的状态,但是也有的胚胎就不会在继续进行生长发育了,就属于是早期的囊胚,因此囊胚和融合胚胎还是不同的,要注意区分。
试管婴儿融合胚胎可不可以移植
试管婴儿融合胚胎是可以进行移植的,融合胚胎本身的质量就是不错的,属于是早期的囊胚,胚胎中的细胞数量是比较多的,因此是非常适合进行移植的。
融合胚胎发育潜能好移植成功率高
另外有相关数据显示融合期的胚胎就有较高的发育潜能,因此是可以在一定程度上提高胚胎的种植率和成功率的,也就是说试管移植融合胚胎的成功率是非常高的。
Tips:
一般在患者取卵取精之后医生就会将精卵进行结合培养逐渐形成胚胎,形成胚胎之后医生会电话或者是短信的方式告知患者胚胎的质量和等级,具体移植哪个胚胎还是需要结合患者的实际情况而定,患者只需要积极配合医生即可。

发表评论